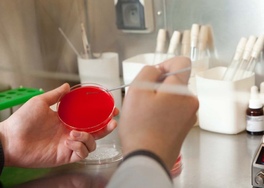
img

- Главная
- Малахова Виктория Юрьевна
Малахова Виктория Юрьевна

Клинические интересы
Владеет всеми методами диагностики и лечения бесплодия, современными методами экстракорпорального оплодотворения и переноса эмбрионов в полость матки, особенностями схем стимуляции суперовуляции.
Образование
- 2013 — окончила Витебский государственный ордена Дружбы народов медицинский университет по специальности «Лечебное дело».
Последипломное образование
- 2012 — обучалась в субординатуре на кафедре «акушерства и гинекологии», занималась изучением вопроса: «Иммунологическое механизмы патогенеза эндометриоза, лечение» под руководством профессора Радецкой Л.Е.
- 2014 — закончила интернатуру по специальности «акушерство и гинекология» на базе Витебского областного клинического родильного дома.
Повышение квалификации
- 2015 — сертификационный цикл на факультете последипломного образования РУДН им. Патриса Лумумбы г. Москва. Сертификат по специальности «Акушерство и гинекология».
- 2015 — получила диплом первичной переподготовки по специальности «Ультразвуковая диагностика» на базе факультета последипломного образования РУДН им. Патриса Лумумбы.
- 2020 — сертификационный цикл на факультете последипломного образования РУДН им. Патриса Лумумбы г. Москва. Сертификат по специальности «Акушерство и гинекология».
- 2020 — образовательный модуль « Профилактика , диагностика и лечение новой короновирусной инфекции».
- 2020 — участник ХХХII Ежегодной международной конференции РАРЧ « Репродуктивные технологии сегодня и завтра»
- 2020 — участник ХХII Всероссийского научно-образовательного форума « Мать и Дитя -2022»
Достижения
- Является членом Ассоциации Репродукции Человека (РАРЧ).
- Регулярный участник конгрессов по репродуктивной медицине.
Статьи врача
Хронический микоплазмоз
Воспалительные заболевания мочеполовой системы женщин и мужчин довольно распространены в наше время. В частности это заболевания вызванные микоплазмами. Многие практические врачи и исследователи изучают этот вопрос.
Микоплазма виды
Mycoplasma в переводе означает, от греческого mykes – грибок в сочетании со вторым словом plasma – нечто образованное, сформированное.
Респираторный микоплазмоз у взрослых и детей
Микоплазмозы – это группа заболеваний, которые вызываются микоплазмами. Самым частым заболеванием является респираторный микоплазмоз.